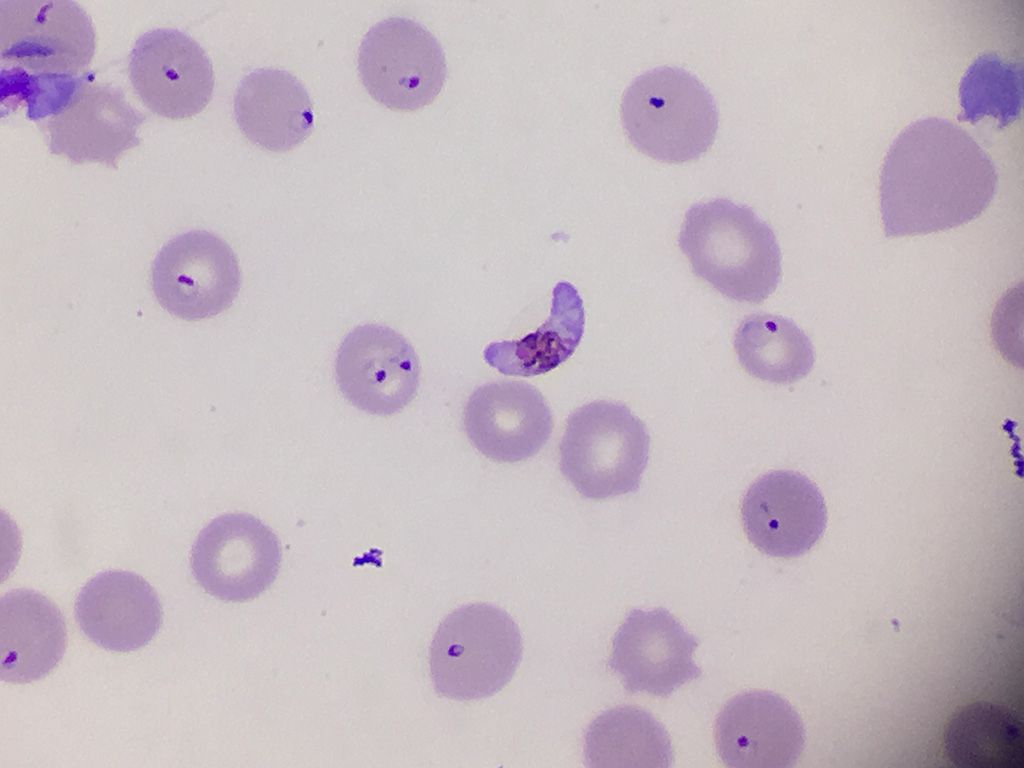
Malaria

Ziektes
Test je kennis: typ je antwoord bij elke vraag en klik op controleren.

Met de volgende vraag gaan we de medische toer op. Tegenwoordig worden kinderen vanaf de geboorte hiervoor ingeënt, maar toch komt deze ziekte vaak nog voor, vooral dan in de armere landen. Het gaat om kinderverlamming, een ontsteking van de grijze stof in het ruggenmerg. Onder welke naam staat deze ziekte beter bekend?

Ik ben op zoek naar de seksueel overdraagbare aandoening, waarbij één van de verschijnselen het afscheiden van geelgroen pus is. Vandaar dat de andere benaming van deze ziekte ook wel 'druiper' is.

Voor deze vraag zijn we op zoek naar een syndroom dat zich kenmerkt door beperkingen in de sociale interacties, interesses en activiteiten. Er is er sprake van een normale tot hoge intelligentie en, anders dan bij de klassieke vorm van autisme, een gemiddelde neiging tot het maken van contact. Diegenen die de film Ben X gezien hebben, kennen ongetwijfeld het antwoord.

We zoeken een relatief zeldzame infectieziekte die vooral voorkomt bij kinderen tussen de 3 en 12 jaar. Het ziekteverloop is plotselinge koorts en keelpijn, hoofdpijn, misselijkheid en braken, één dag na het uitbreken van de ziekte ontstaan op de huid op warme lichaamsplaatsen spikkels die soms jeuken, opvallend rode wangen en een witte driehoek rond de mond en onder de neus. Na vijf dagen verdwijnen de vlekjes en de koorts. Op het hoogtepunt van de ziekte is de tong vuurrood en gezwollen.

We zoeken een infectieziekte die door steekmuggen wordt verspreid. Tot 50 % van de geïnfecteerde komt te overlijden wanneer de ziekte niet behandeld wordt. De ziekte komt alleen in Afrika ten zuiden van de Sahara (ca. 180.000 gevallen per jaar) en Zuid- of Midden-Amerika (ca. 20.000 gevallen per jaar) voor. Jaarlijks worden naar schatting 84.000 tot 170.000 mensen met het virus besmet waarvan er rond de 60.000 komen te overlijden. Welke infectieziekte zoeken we? En de winnaar van de ronde van Frankrijk heeft er ook soms last van?

Welke leverontsteking is zeer besmettelijk en veroorzaakt geel oogwit en gele huid na enkele dagen. De kleur van de urine is cola-achtig en de ontlasting is licht gekleurd zoals stopverf. De virale besmetting gebeurt rechstreeks door bemesting of indirect via handen die voorwerpen besmetten.

Deze psychische aandoening tast het vermogen aan om de werkelijkheid en de eigen perceptie van gebeurtenissen uit elkaar te houden. Niet alleen het denken en het gedrag zijn aangetast, maar ook het gevoelsleven en het humeur.De term die we zoeken, werd voor het eerst voorgesteld door Eugen Bleuler.

We zoeken een psychiatrisch syndroom waar in de meeste gevallen de moeder, haar kind mishandelt. Zij verzint of veroorzaakt een ziekte bij haar kind om op die manier zelf aandacht te krijgen van medisch personeel. Het kind krijgt hierdoor onnodig pijnlijke onderzoeken. Er zijn zelfs voorbeelden bekend waarbij kinderen tientallen onnodige operaties hebben moeten ondergaan.

Deze medische term staat voor de zucht naar het consumeren van niet-eetbare dingen, zoals aarde, haar, steentjes, munten of verfschilfers die van houtwerk worden gepeuterd. De patiënten vertonen geen afkeer van gewoon voedsel. De naam komt van de Latijnse naam voor ekster, een vogel die ook bijna alles eet.

Michael Jackson leed aan een huidziekte. Ook zijn biologische zoon, Prince Jackson, lijdt aan deze ziekte. Aan welke huidziekte leed Michael Jackson?

In 2018 stierf Stephen William Hawking. Hij was een Brits natuurkundige, kosmoloog en wiskundige. Hij is het bekendst vanwege zijn werk op het gebied van zwarte gaten en singulariteiten in de kosmologie. Maar helaas ook door zijn ziekte, in 1962 kreeg hij een ongeneeslijke ziekte die de zenuwcellen aantast totdat het lichaam helemaal is verlamd. Graag de naam (of afkorting) van deze ziekte

Eind 2019 vond in het Chinese Wuhan een uitbraak plaats van een tot dan toe onbekend virus. Het aantal besmettingen en doden liep snel op begin 2020. Wat is de naam van dit virus?

Chorea van Sydenham, ook wel chorea minor genoemd, is een zeldzame neurologische aandoening die vooral bij kinderen voorkomt en vaak samenhangt met acuut reuma na een streptokokkeninfectie. De ziekte veroorzaakt schokkerige, dansende bewegingen van het gezicht en de ledematen, en de symptomen houden doorgaans 6 weken tot 12 maanden aan. Vroeger werd deze aandoening vernoemd naar een vierde-eeuwse Siciliaanse heilige, die als een van de veertien heilige genezende helpers wordt gezien binnen de katholieke traditie. Weet jij de vroegere naam van deze ziekte?

Hoe heet de chronische auto-immuunziekte, gekenmerkt door een versnelde deling en verminderde rijping van hoorncellen in de opperhuid? Omdat de cellen niet normaal uitrijpen is ook het afschilferen verstoord, waardoor lokaal sterke afschilfering van huidschubben op de aangedane plaatsen plaatsvindt.

Hoe heet de seksueel overdraagbare ziekte waarbij blaasjes komen op de genitaliën en de lippen?
Van welke besmettelijke ziekte is de naam afgeleid van het Latijns voor slechte lucht?


Antrax is een infectieziekte die wordt veroorzaakt door de bacterie Bacillus Anthracis. De ziekte is bij mensen en dieren al héél lang bekend en was zelf een van de eerste ziekten waarvan werd aangetoond dat ze werd veroorzaakt door een bacterie. Maar onder welke naam kennen wij antrax nog?

Wat is het psychologisch verschijnsel dat soms optreedt tijdens een gijzeling of gevangenname? Het verschijnsel houdt in dat de gegijzelde sympathie voor de gijzelnemer krijgt.

Wat is de naam van het virus dat voornamelijk wordt overgebracht door vrouwelijke steekmuggen? Het virus is over het algemeen een milde aandoening waar geen behandeling voor is. Er zijn echter aanwijzingen dat besmetting met het virus ernstige gevolgen voor de menselijke gezondheid kan hebben, met name voor de foetus. Op 1 februari 2016 riep de Wereldgezondheidsorganisatie de uitbraak uit tot een internationale noodsituatie.

Deze zeldzame, autosomale dominante verouderingsziekte wordt veroorzaakt door een mutatie in het LMNA-gen. De ziekte is zeer zeldzaam en treft naar schatting 1 op de 4 miljoen geboren kinderen. Welk woord komt uit het Grieks en betekent: "sneller oud worden"?

Als je er als man geen meer kan krijgen, is er iets mis. Gelukkig bestaan er oplossingen voor. Pilletjes bijvoorbeeld, van die blauwe (hebben we ook maar van horen zeggen). Het tegenovergestelde is echter ook niet goed. Duurt het langer dan zes uur, dan kunnen bepaalde onderdelen zelfs voorgoed afsterven. Wat is de wetenschappelijke term voor het hebben van een zeer langdurige erectie?

Hoe heet een neurologische stoornis die gekenmerkt wordt door uitgebreide, matige tot soms ernstige tics?

Dit zeldzame syndroom werd voor het eerst beschreven in 1956 door twee Zwitserse artsen. Patiënten hebben last van een onbedwingbare en onverzadigbare eetlust, als gevolg van een genetische afwijking. Hoe heet dit syndroom? ‘Het Michelin-syndroom’ is alvast geen goed antwoord.

Dat dit het symbool is voor AIDS hoeven we niet te weten. Dat AIDS een vorm van immanente rechtvaardigheid zou zijn, houden we voor rekening van gefrustreerde, soutanes dragende fans van de collectieve waanzin die we godsdienst noemen. A.I.D.S. is een acroniem, dat weten de meesten onder u waarschijnlijk wel. Maar waarvoor staan die vier letters?